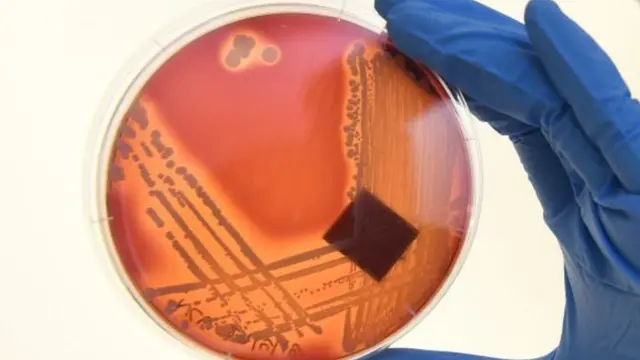

کشف آنتیبیوتیکهای بسیار قوی با استفاده از هوش مصنوعی
منبع تصویر، Getty Images
پژوهشگران میگویند با استفاده از هوش مصنوع آنتیبیوتیکهایی بسیار قوی کشف کردهاند که میتوانند بر برخی از باکتریهای مقاوم موثر باشند.
این پژوهش در دانشگاه امآیتی در آمریکا صورت گرفته و برای اولین بار با "رها کردن هوش مصنوعی در کتابخانه دیجیتال ترکیبهای شیمیایی" ترکیب آنتیبیوتیکهای جدید کشف شده است.
آزمایشهای صورت گرفته نشان داده است که این ترکیب جدید میتواند طیف وسیعی از سویههای باکتری از جمله Acinetobacter baumannii و Enterobacteriaceae را نابود کند.
این دو باکتری از جمله سه باکتریای هستند که سازمان بهداشت جهانی به خاطر مقاومتشان در برابر آنتی بیوتیکهای معمولی آنها را "بحران ساز" توصیف کرده است.
یکی از پژوهشگران این طرح، استفاده از چنین روشی را در عرصه کشف آنتیبیوتیکها بیسابقه دانست و گفت آنتیبیوتیک جدید از قویترین آنتیبیوتیکهایی است که تاکنون کشف شده است.
مقاومت یک باکتری در برابر آنتیبیوتیک نتیجه جهش ژنتیکی آن باکتری است که باعث میشود مواد شیمیایی که قبلا قادر به نابودی آن بوده دیگر تاثیر نداشته باشد. به گفته کارشناسان سازمان بهداشت جهانی، بدون کشف آنتیبیوتیکهای موثر ممکن است تا سال ٢٠٥٠ هر سال زندگی بیش از ده میلیون نفر در جهان در معرض خطر جدی قرار گیرد.
شیوه انجام پژوهش
برای کشف آنتیبیوتیک جدید، پژوهشگران یک "آلگوریتم یادگیرنده" را آموزش دادند تا باکتریها را شناسایی کند. برای این منظور لازم بود که خصوصیات مولکولی و اتمی حدود ٢٥٠٠ داروی شیمیایی و گیاهی را وارد این الگوریتم کنند و کارآیی آنها را در متوقف کردن رشد باکتری E.Coli بسنجند.
پس از آنکه این آلگوریتم خصوصیات یک آنتیبیوتیک موثر را یاد گرفت، پژوهشگران آن را "در کتابخانه حاوی بیش از شش هزار ترکیب شیمیایی مورد استفاده در درمان بیماریهای مختلف انسان رها کردند." به این ترتیب به جای اینکه این الگوریتم به جستجوی مواد بالقوه موثر بر باکتریها برآید، به جستجوی موادی پرداخت که در نابودی باکتریها موثر بودهاند اما شباهتی به آنتی بیوتیکهای کنونی نداشتند.
به این ترتیب، این احتمال افزایش یافت که داروی جدید به شکلی متفاوت از داروهای کنونی عمل کند و بتواند بر باکتریهای مقاوم در برابر این داروها تاثیر بگذارد.
نتیجه این فرآیند کشف بیست و سه ترکیب جدید برای ساخت آنتیبیوتیکهای بالقوه بود که از آن میان به نظر میرسد که دو ترکیب بسیار موثرند.
پژوهشگران در حال حاضر در نظر دارند از همین الگوریتم برای یافتن "آنتیبیوتیکهای اختصاصی" استفاده کنند. آنتیبیوتیک اختصاصی فقط بر باکتری مورد نظر تاثیر میگذارد و باعث نابودی باکتریهای مفیدی نمیشود که در روده بزرگ انسان وجود دارند.
به گفته پژوهشگران در مجموع، این طرح توانست اهمیت کشف دارو با استفاده از کامپیوتر را نشان دهد. یکی از پژوهشگران گفت بدون استفاده از کامپیوتر، آزمایش بیش از یکصد میلیون ترکیب شیمیایی برای تشخیص آثار آنها بر باکتریهای مختلف امکانپذیر نبود.











